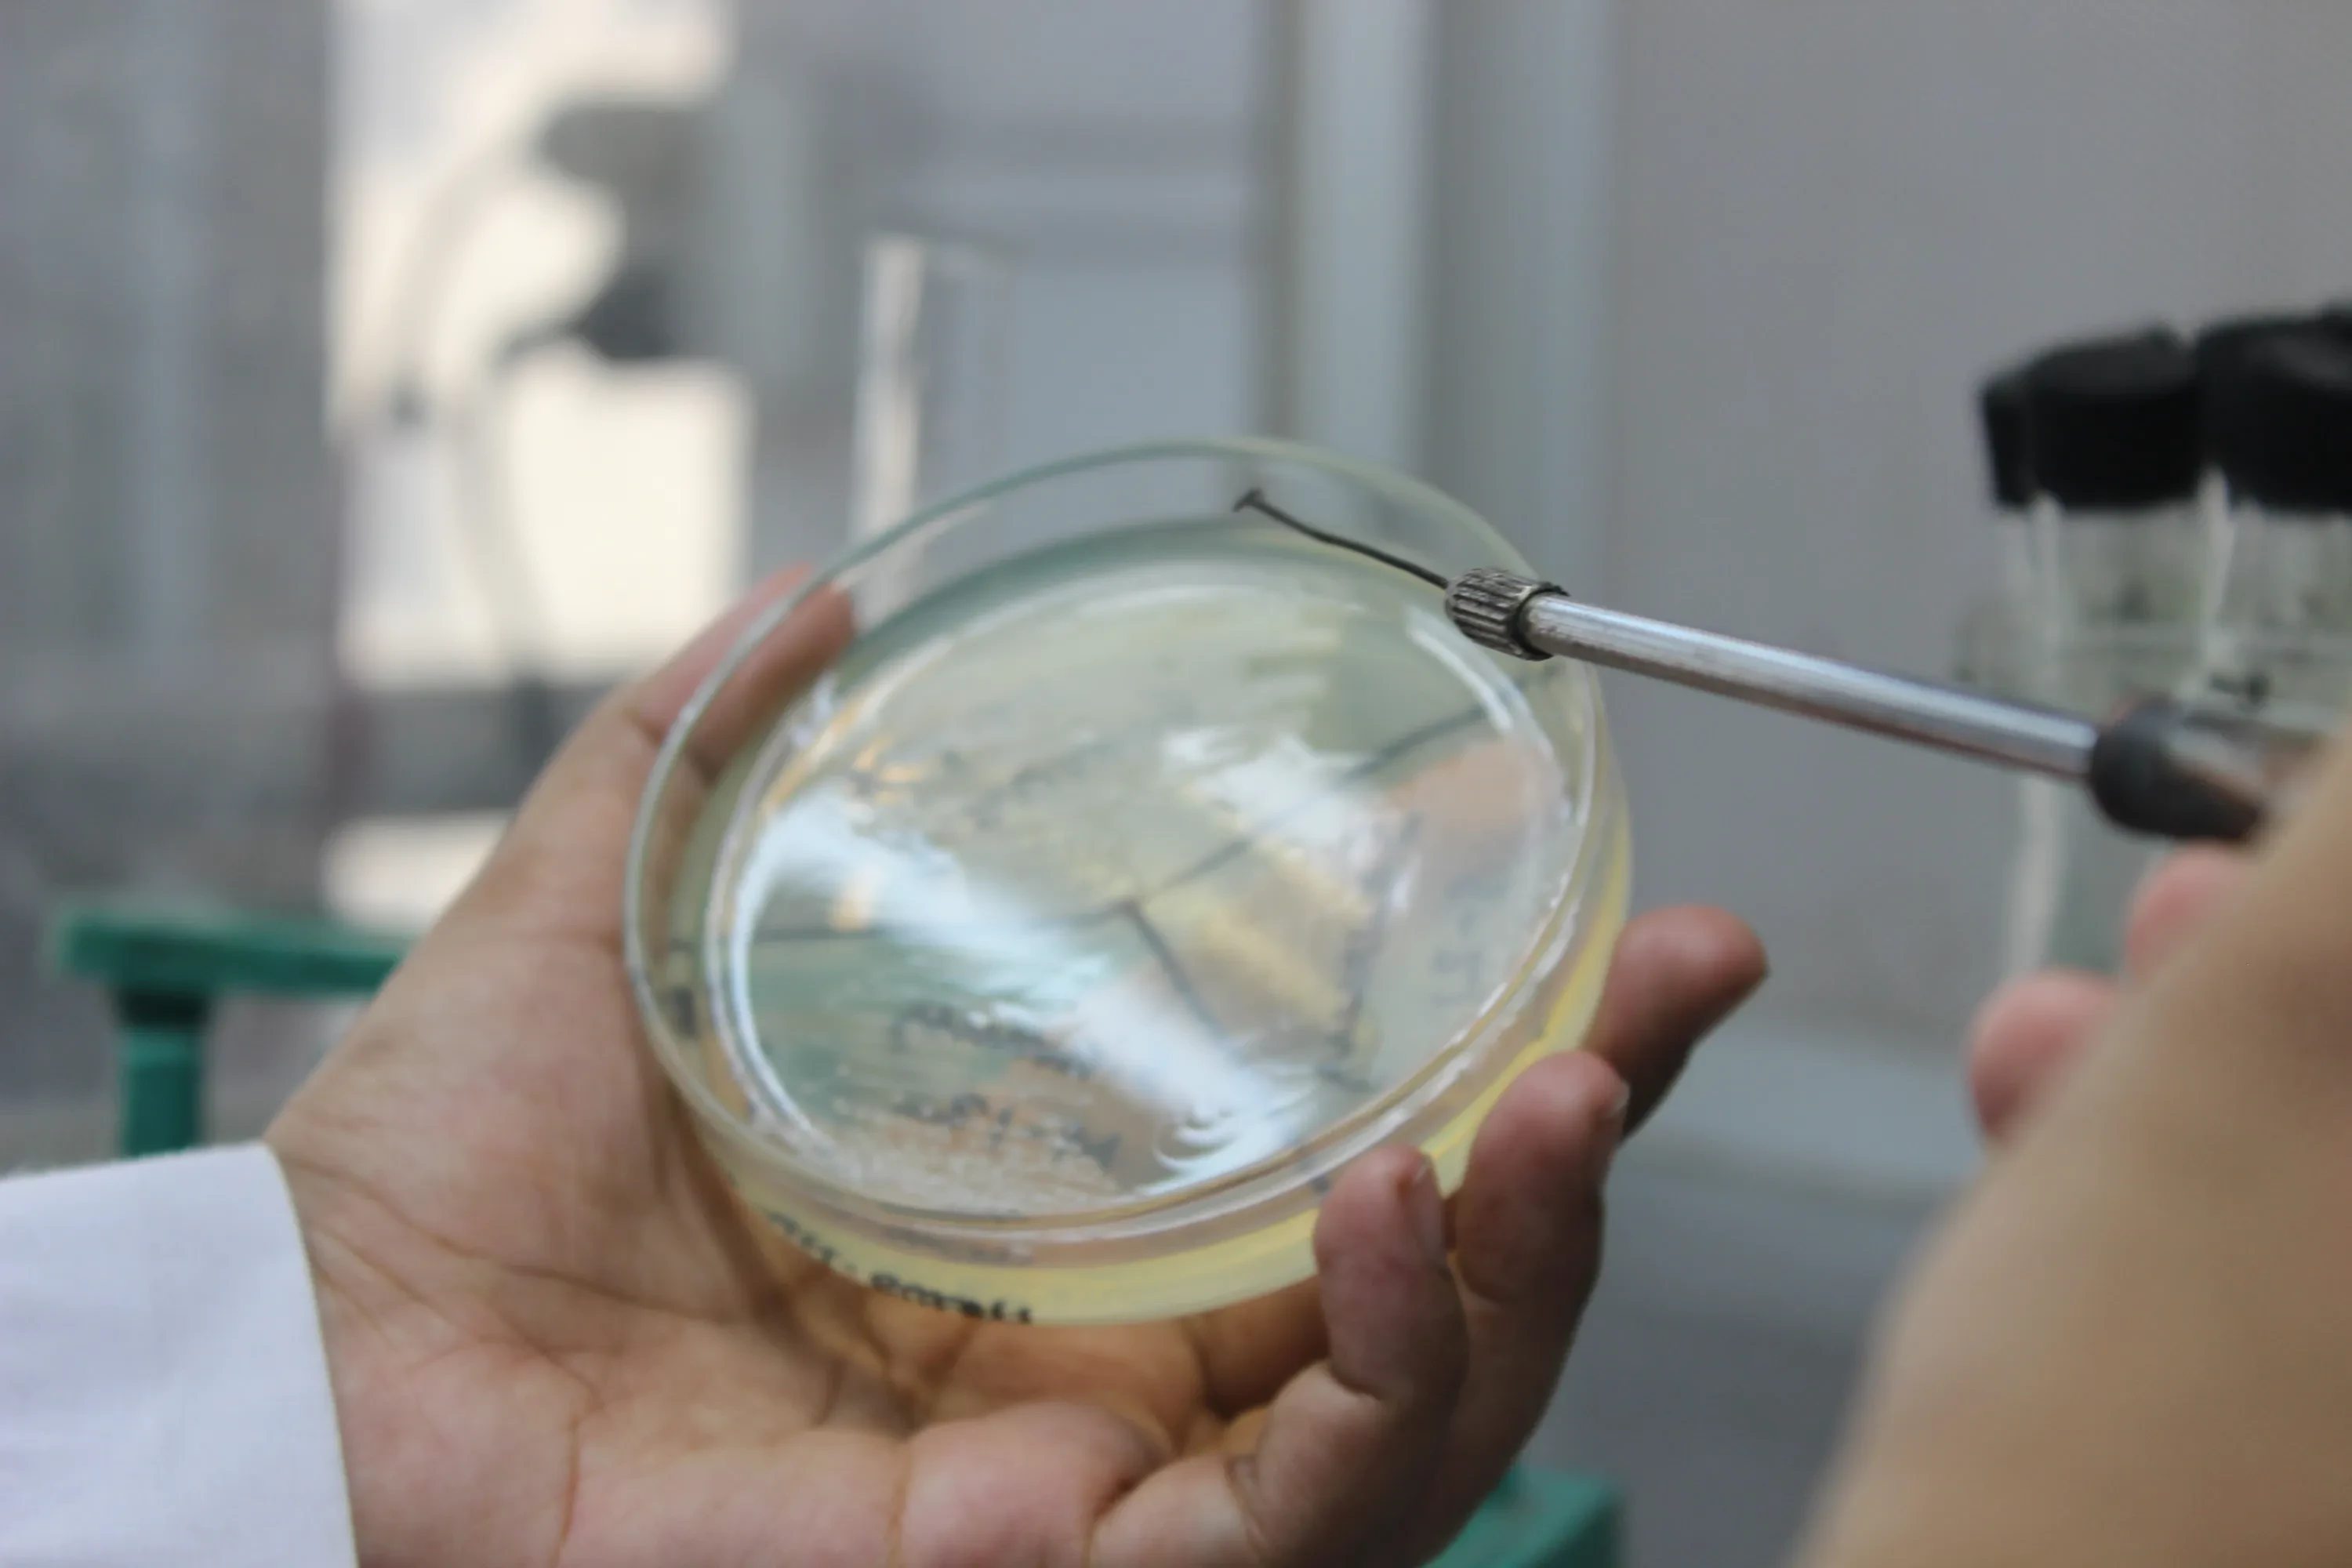

Primeasia University
Computer Club
Founded in 2003, Primeasia University (PaU) is a leading educational institution in Bangladesh. With a strong focus on quality education, research, and practical experience, PaU has grown to accommodate nearly 4,000 students and 200 faculty members. The Primeasia University Computer Club aims to foster a deep understanding of computer science and information technology among its members. Through workshops, coding competitions, and collaborative projects, the club provides students with hands-on experience and the latest industry knowledge. This prepares students for successful careers in the tech industry, enhancing their problem-solving skills and technical expertise.
Primeasia University
Robotics Club
As one of Bangladesh's best private universities, PaU prioritizes students and the community while excelling in science, technology, and business. The Primeasia University Robotics Club reflects this ethos by offering students the opportunity to engage with cutting-edge robotics technology. The club encourages innovation and creativity through participation in national and international robotics competitions, workshops, and research projects. By developing skills in automation, AI, and mechanical design, the Robotics Club aims to produce leaders in the field of robotics who can contribute to technological advancements and societal development.

Primeasia University
Sports Club
Believing that education cannot be achieved only in the classroom, PaU encourages co-curricular and extracurricular activities. The Primeasia University Sports Club plays a vital role in promoting physical fitness, teamwork, and sportsmanship among students. By organizing various sports events, tournaments, and fitness programs, the club ensures a well-rounded university experience. It fosters a sense of community and camaraderie, contributing to the mental and physical well-being of students. The Sports Club is instrumental in identifying and nurturing athletic talent, making significant contributions to the university's vibrant campus life.
Primeasia University
Debate Club
As part of PaU's commitment to excellence, the Primeasia University Debate Club focuses on enhancing students' critical thinking, public speaking, and argumentative skills. The club provides a platform for students to engage in intellectual discussions and debates on a variety of topics, from current events to philosophical questions. By participating in local and international debate competitions, members gain confidence and develop persuasive communication skills. The Debate Club embodies PaU's values of professionalism, discovery, creativity, and respect, fostering a culture of informed and articulate individuals who can contribute meaningfully to society.

Primeasia University
Cultural Club
Founded in 2003, Primeasia University (PaU) is a leading educational institution in Bangladesh. The Primeasia University Cultural Club celebrates the rich and diverse cultural heritage of Bangladesh and beyond. Through organizing cultural events, festivals, and artistic performances, the club promotes cultural awareness and appreciation among students. It provides a platform for students to express their creativity and talents in music, dance, drama, and visual arts. The Cultural Club plays a crucial role in enriching campus life, fostering a sense of identity and belonging, and enhancing the overall educational experience at PaU.
Primeasia University
Business Club
As one of Bangladesh's premier private universities, PaU excels in business education through its Primeasia University Business Club. The club offers students practical exposure to the business world through workshops, seminars, and networking events with industry professionals. By fostering entrepreneurial skills and business acumen, the club prepares students for successful careers in various business sectors. The Business Club emphasizes ethical practices, social responsibility, and innovative thinking, aligning with PaU's mission to produce competent and ethical business leaders who can positively impact the national and global economy.

Primeasia University
Photography Club
At PaU, education extends beyond the classroom to include a variety of co-curricular and extracurricular activities. The Primeasia University Photography Club nurtures students' passion for photography and visual storytelling. Through photo walks, exhibitions, and photography contests, the club provides a platform for students to hone their skills and showcase their work. The club encourages creativity, attention to detail, and a unique perspective on the world. By capturing moments that tell compelling stories, the Photography Club contributes to the vibrant cultural fabric of the university and enhances students' artistic expression.
Primeasia University
Language Club
PaU's commitment to diverse and inclusive education is reflected in the Primeasia University Language Club. The club promotes linguistic and cultural diversity by offering students opportunities to learn new languages and explore different cultures. Through language classes, cultural exchange programs, and linguistic workshops, members develop proficiency in various languages, enhancing their communication skills and cultural understanding. The Language Club prepares students for global engagement, fostering a sense of global citizenship and intercultural competence, which are essential in today's interconnected world.


Primeasia University
Engineering Club
Founded in 2003, Primeasia University (PaU) is a leading educational institution in Bangladesh. The Primeasia University Engineering Club is dedicated to advancing students' knowledge and skills in engineering and technology. By organizing technical workshops, engineering competitions, and collaborative projects, the club provides practical experience and fosters innovation. The club encourages interdisciplinary learning and problem-solving, preparing students for successful careers in engineering fields. Through its activities, the Engineering Club contributes to the university's mission of achieving academic excellence and technological advancement.
Primeasia University
Social Welfare Club
PaU is committed to social responsibility and community engagement, as exemplified by the Primeasia University Social Welfare Club. The club focuses on addressing social issues and improving the quality of life for marginalized communities. Through volunteer work, awareness campaigns, and community service projects, members actively contribute to social development and welfare. The Social Welfare Club instills a sense of compassion, empathy, and civic duty in students, aligning with PaU's values of outreach and service. By fostering a culture of social responsibility, the club plays a crucial role in shaping well-rounded and socially conscious graduates.

Primeasia University
Science Club
Recognizing that education goes beyond traditional classroom settings, PaU encourages students' interests in various fields through clubs like the Primeasia University Science Club. The club promotes scientific inquiry and research by organizing experiments, science fairs, and guest lectures from experts. Members engage in hands-on activities that enhance their understanding of scientific principles and foster a passion for discovery. The Science Club aims to inspire future scientists and innovators who can contribute to scientific advancements and address global challenges. By nurturing curiosity and critical thinking, the club plays a vital role in the academic and personal growth of students.
Primeasia University
Law & Moot Club
PaU's dedication to academic excellence and community service is embodied in the Primeasia University Law & Moot Club. The club provides a platform for law students to develop their legal skills through moot court competitions, legal debates, and workshops. Members gain practical experience in legal research, argumentation, and courtroom procedures, preparing them for successful careers in law. The Law & Moot Club emphasizes professionalism, ethical practices, and a commitment to justice. By fostering a deep understanding of legal principles and practices, the club contributes to the development of competent and ethical legal professionals.
